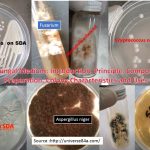
SDA Fungal Medium: Introduction, Principle, Composition, Preparation, Colony Characteristics and Uses

Tag: Sabouraud Dextrose Agar
SDA Fungal Medium: Introduction, Principle, Composition, Preparation, Colony Characteristics and Uses
 Introduction of SDA SDA stands for Sabouraud Dextrose Agar and Sabouraud...
Introduction of SDA SDA stands for Sabouraud Dextrose Agar and Sabouraud...
Introduction of SDA SDA stands for Sabouraud Dextrose Agar and Sabouraud...
Introduction of SDA SDA stands for Sabouraud Dextrose Agar and Sabouraud...